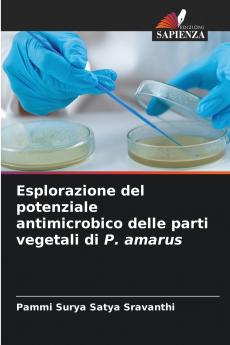
Esplorazione del potenziale antimicrobico delle parti vegetali di P. amarus

Italian
Paperback
₹8052
₹10630
24.25% OFF
(All inclusive*)
Delivery Options
Please enter pincode to check delivery time.
*COD & Shipping Charges may apply on certain items.
Review final details at checkout.
Looking to place a bulk order? SUBMIT DETAILS
About The Book
Description
Author
I metaboliti secondari delle piante si sono dimostrati una fonte inestimabile di prodotti farmaceutici grazie alle loro diverse proprietà biologiche ovvero effetti antivirali antibatterici antiossidanti e antitumorali. I metaboliti secondari sono fonti uniche per prodotti farmaceutici additivi alimentari aromi e altri prodotti industriali. L'importanza commerciale di questi metaboliti secondari ha suscitato negli ultimi anni un grande interesse nell'esplorazione delle loro possibilità. Terpenoidi alcaloidi fenoli e flavonoidi sono alcuni dei composti bioattivi che contribuiscono al valore medicinale di una pianta. L'erba Phyllanthus amarus è ampiamente utilizzata nei paesi tropicali compresa l'India. Ha importanti usi tradizionali. Considerando il vasto potenziale di questa pianta come fonte di farmaci antimicrobici il presente studio si propone di fornire una panoramica dell'analisi fitochimica e delle proprietà antimicrobiche del Phyllanthus amarus che può essere utile per ulteriori studi su questa pianta.
Delivery Options
Please enter pincode to check delivery time.
*COD & Shipping Charges may apply on certain items.
Review final details at checkout.
Details
ISBN 13
9786137363058
Publication Date
-30-09-2025
Pages
-96
Weight
-142 grams
Dimensions
-152x229x5.84 mm